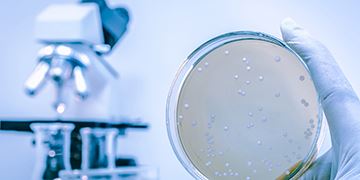

Water Filtration for Food Processing & Bottling
Purified water is essential to food and beverage production, not only for taste reasons, but also to ensure safe, healthy consumption and increased shelf life of food products.
Working closely with the food processing and bottling industry, Aquastream provides quality water filtration and treatment solutions for many areas including bottling plants, beverage manufacturers and ice production facilities.
With solutions for scale control, disinfection, taste & odour correction, water softening, and bacteria elimination, our team will advise best practice and fail-safe solutions for your application.
Solutions for Bottling Plants
Ensuring consistent water quality is important to ensure product quality and food safety requirements are achieved.
Providing trusted solutions for bacterial control, taste and odour correction and disinfection for bottle washing, dilution water and rinsing processes.
Replacement filtration cartridges and systems for general and sterile applications, our technicians assist with product selection and recommendations.
Our range of products for Bottling Plants
Solutions for Ice Manufacturing
Producing high quality ice for food packaging and human consumption can be challenging.
Providing trusted filtration solutions and treatment for bore water and rainwater systems, Aquastream helps plant managers with a single source supply of replacement filter bags and cartridges as well as ultraviolet disinfection systems and supply.
Consult with our trained filtration team to find the right filtration and treatment solution and supplies.



.jpg)